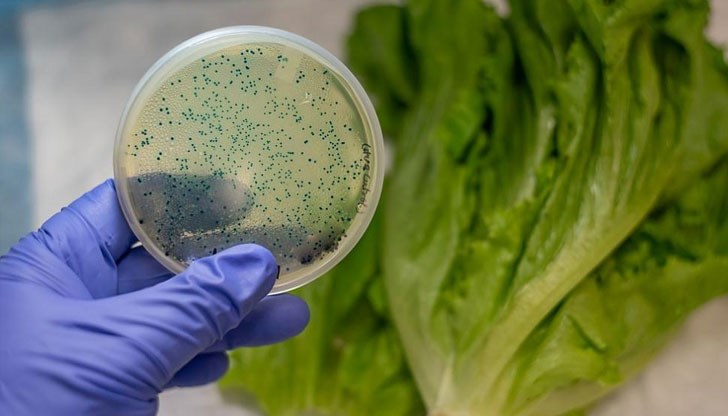
Може ли да консумираме немити зеленчуци? А храни, които са леко мухлясали? Какво трябва да знаем, когато приготвяме месо? И как да избегнем разпространяването на бактерии в кухнята? Може ли да консумираме немити зеленчуци? А храни, които са леко мухлясали? Какво трябва да знаем, когато приготвяме месо? И как да избегнем разпространяването на бактерии в кухнята?

Какво трябва да знаем за бактериите в храните?
- Редактор: Петя Георгиева
- Коментари: 0
Може ли да консумираме немити зеленчуци? А храни, които са леко мухлясали? Какво трябва да знаем, когато приготвяме месо? И как да избегнем разпространяването на бактерии в кухнята?
Отговорите дава Deutsche Welle:
Афлатоксините - отровата от плесенните гъби
Някои видове микроскопични гъби от групата Aspergillus произвеждат изключително опасни токсини - най-силните от всички биологични отрови. Плесенните гъби се появяват обичайно по орехите и другите ядки, по зърнените култури като царевица и жито, по семената. Ако в кухнята ви има мухлясали храни - дори и само отчасти, най-добре ги изхвърлете.
Смъртоносната плесен
Дори и в малки дози приемането на афлатоксини може да причини сериозни заболявания - като рак на черния дроб, или пък да доведе до нарушения в развитието на плода в майчината утроба. Високата концентрация на този токсин предизвиква остро отравяне, нерядко с летален изход.
Салмонелите
Бактериите от групата Salmonella живеят в стомашно-чревния тракт на много животни. Но за човека ентеробактериите често водят до тежки заболявания. Строгото спазване на правилата за хигиена в кухнята, както и топлинната обработка (15 минути са достатъчно) най-вече на месните и рибните продукти помагат да се избегне разпространението на салмонелите.
Опасните чревни пръчици
От една страна бактериите от групата Escherichia coli изпълняват важни функции в червата на човека. Но при хората с отслабена имунна система особено опасният високопатогенен щам на пръчковидните бактерии (ентерохеморагична ешерихия коли) може да предизвика тежка чревна инфекция.
Коварната салата
Високата температура може да унищожи и салмонелите, и чревните причици. За съжаление обаче бактерии има не само в продуктите от животински произход, но и в зеленчуците. Преди употреба марулите, краставиците и всички останали зеленчуци трябва внимателно да се измият с топла вода. Важно е да се използват различни ножове за зеленчуци и месо. Това помага за намаляване на риска от зараза.
Листериите
Пръчковидните бактерии от групата Listeria са известни със способността си да се приспособяват перфектно. Те фактически са навсякъде, включително в хранителните продукти. В организма на човека те са способни да предизвикат заразяване на кръвта или менингит (възпаление на кората на главния мозък). Листериите могат да бъдат победени чрез термична обработка - на 70 градуса за най-малко десет минути.
Норовирусът
Вирусът Норовирус или Норфолк от групата на норовирусите много често е виновник за разпространението на "стомашното разстройство" с гадене, повръщане и диария. Вирусът може да живее до 12 дни по зеленчуците и месните продукти. Борбата с него се води отново чрез термичната обработка и дезинфекцията на ръцете.
Чистите ръце - залог за здраве
Хранителните продукти влизат в съприкосновение с микробите още докато се обработват. Най-вече в собствената кухня. Затова спазването на хигиената е най-добрият начин за борбата с бактериите и вирусите. Най-важното е ръцете да бъдат измити внимателно със сапун, преди да се пристъпи към приготвянето на храната.
Златните правила на кухненската хигиена
След като веднъж сте размразили продукти, не бива да ги замразявате наново. За рязането на месото, рибата и зеленчуците трябва да се използват различни дъски - така може да се предотврати пренасянето на бактериите към продуктите, които не изискват термична обработка. Месото и рибата трябва да се готвят не по-малко от десет минути (на не по-малко от 70 градуса) и трябва да се изяждат още същия ден!
























Съдът нареди екооценка за новата асфалтова база в Червена...
Започна строеж на жилищни сгради в Парка на младежта
Слави Трифонов: Подкрепихме референдума за еврото, за да...
Съдът нареди екооценка за новата асфалтова база в Червена...
Слави Трифонов: Подкрепихме референдума за еврото, за да...